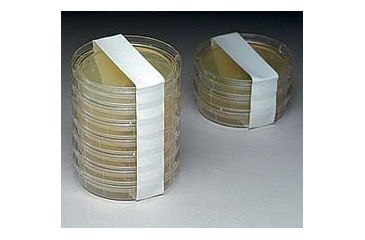
Image of Micronova Tape Wht Slvsl 1X18YD Irrd CSLB-1WHIR

Tap Tap to Zoom
Product Info for Micronova Tape Wht Slvsl 1X18YD Irrd CSLB-1WHIR
Micronova Tape Wht Slvsl 1X18YD Irrd CSLB-1WHIR is one of the many quality laboratory and scientific products we have to offer at very competitive pricing. Micronova Tape Wht Slvsl 1X18YD Irrd CSLB-1WHIR / 68400-434 is part of a wide selection of Micronova Packaging pouches or bags. Combining excellent quality with an affordable price, the Micronova Tape Wht Slvsl 1X18YD Irrd CSLB-1WHIR / 68400-434 can meet your scientific research needs while still offering a good value for a budget conscious end user. If you have any questions about any of our Packaging pouches or bags please do not hesitate to contact our customer service for further guidance.![]()
Conformable, irradiated polyethylene tape ensures an effective seal between the glove and garment in cleanroom gowning. Perforations at 7.6cm (3") intervals allow users to bind and tear at optimum lengths to secure the glove. Low-outgassing polyethylene film removes cleanly, leaving no adhesive residue. Wound on a 7.6cm (3") plastic core with no liner. Tape seals approximately 42 gloves (21 applications). Length: 16.5m (18yds.). Color: white.
Tape comes with full certification of irradiation and lot traceability.
Available options for Micronova Tape Wht Slvsl 1X18YD Irrd CSLB-1WHIR
- Micronova Tape Wht Slvsl 1X18YD Irrd CSLB-1WHIR, Each
- Micronova Tape Wht Slvsl 1X18YD Irrd CSLB-1WHIR, Case
Specifications for Micronova Tape Wht Slvsl 1X18YD Irrd CSLB-1WHIR:
| Width, cm (in.): | 2.5 (1) |
| Micronova No.: | CSLB-1WHIR |
| Unit: | Case of 36 / Each |